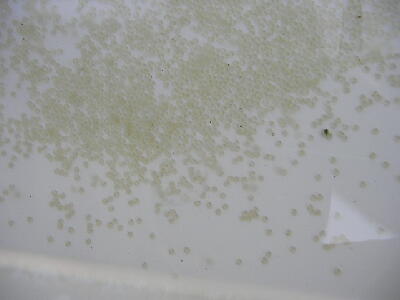

2月10日(2007年 冬眠と一回目の水換え)
今日は、今年の種魚の一回目の水換えをしました。
この二匹は昨年の地元の会(明鱗会)で使った後に抗ヘルペス剤で養生してからずっと隔離し
て飼育してきました。
て飼育してきました。
今年の期待のペア(雌親にそっくりな子をたくさん作りたい!)であり、また抗ヘルペス剤を使
用しての養生試験の続きでもあります。
用しての養生試験の続きでもあります。
まずは、昨年の12月3日の画像です。(冬眠準備完了時)
 |
 |
今年の冬眠は舟によっていろいろな冬眠方法を試していました。
普通飼育の青水での冬眠。装置を使用して青水を作り冬眠中は装置をはずしての冬眠。
装置を使っての冬眠。装置とサーモ・ヒーターを使っての冬眠。
装置とサーモ・ヒーター両方を使っての冬眠はこの舟と錦蘭会出品魚の二舟だけでした。
サーモはレーシーを使用して3℃に設定していたのですが・・・
なーんと!今年は水温が3度を切る事が一度もなく非常に高価な水温計の役目にしかなりま
せんでした。でも今後産卵に向けての水温管理には役立つと思います。
せんでした。でも今後産卵に向けての水温管理には役立つと思います。
さて本日の水換えの様子ですが、二ヶ月ぶりに魚とのご対面になりました。
冬眠中に病気をした形跡が全く無く低水温時によく起こるにきびや色素沈着もありません。
 |
 |
新水と青水の比率は約2対1にしました。
水換え前の青水のPHが9.01で水換え後が8.74です。(天候はうす曇なのでやや低めです)
 |
 |
水換え終了時の舟の様子です。
 |
 |
私の場合は仕事(狂犬病予防注射)の関係でゴールデンウイークにしか選別が出来ないの
で、産卵は四月の上旬を予定しています。(電気代も全然違う。)
で、産卵は四月の上旬を予定しています。(電気代も全然違う。)
よって今月の末までは無理に水温は上げません。急な冷え込み対策として最低水温を5℃に
設定して暖かい日にのみ赤虫を少量与えていく予定です。(マイペース!マイペース!)
設定して暖かい日にのみ赤虫を少量与えていく予定です。(マイペース!マイペース!)
我が家では冬眠中も産卵時も稚魚の育成時にもこの蓋(右上画像)を使っています。
3月9日
2月26日種雄の舟の二回目の水換えの様子です。
 |
 |
ごらんの通りの舟の大きさ(内寸100×90)に対して8匹の魚です。
割り水はご覧の通りです。昨年の4月8日生まれの子達です。
前回紹介した二匹(地元の会の役魚の兄弟魚達です。)
次の画像は4月9日生まれの子達ですが、全くヒーターを使用せずに自然飼育させています。
 |
 |
錦蘭会の役魚の兄弟魚達です。三年前に当歳で導入した愛知のYさんの魚を雄として使って
います。導入したYさんの魚はお色気さんと命名しています。頭は坊主ですが、六枚の鰭は全
て真っ赤で色気のある魚です。系統を信じて二年間、種雄として活躍してもらいました。系統の
力でしょうか?子供達は結構頭が出ています。
います。導入したYさんの魚はお色気さんと命名しています。頭は坊主ですが、六枚の鰭は全
て真っ赤で色気のある魚です。系統を信じて二年間、種雄として活躍してもらいました。系統の
力でしょうか?子供達は結構頭が出ています。
Yさんの系統、恐るべしです。またいずれ画像をUPします。
というかすでに今まで何度も私のコーナーに登場しています。
<3月3日>
待望の今年唯一の導入魚である種雌が我が家にやって来ました。
この魚の魅力は頭もさることながら、我が家には無い筒の太さとヒップのラインの色気を持って
います。おひなちゃんと命名しました。Tさん本当にありがとうございます。
います。おひなちゃんと命名しました。Tさん本当にありがとうございます。
泳ぎもとてもダイナミックです!!!
 |
<3月9日>
おひなちゃんにかけるための雄種の船の三回目の水換えを11日ぶりに行いました。
水換え前の画像はこんな感じです。産卵を遅らせるためにヒーターは最低温度を10度に設定
していました。
していました。
 |
 |
青水が進んで魚の姿が全く見えませんが、装置を使っているので安心していました。
魚はすこぶる元気なのですが、な、な、なーんと!
種雄としてもっとも期待していた二匹が雌でした。しかも何時でも産卵可能なまでに卵が成熟し
ています。お腹も柔らかくなってしまっています。
ています。お腹も柔らかくなってしまっています。
どうすんの!おひなちゃんにかける為の種雄は!自然水温飼育の4月9日生まれの子達の温
度を上げて間に合わすのか?ちょっとあせりぎみのイッシーです。下の画像は実は雌だった!
種雄だった筈の二匹の魚の画像です。自家産の中では特に気に入ってる魚です。・・・残念!
で・・・どうすんの?種雄は?
度を上げて間に合わすのか?ちょっとあせりぎみのイッシーです。下の画像は実は雌だった!
種雄だった筈の二匹の魚の画像です。自家産の中では特に気に入ってる魚です。・・・残念!
で・・・どうすんの?種雄は?
 |
 |
3月20日
<3月10日>
昨日の今日。種雄を求めての大騒動です。ヒーターを入れている舟と入れていない舟。種雄
探しと雌雄の再確認のために4舟の水換えを行ないました。我が家には瞬間湯沸かし器が無
いのでこの時期の水温合わせには本当に苦労します。ヒーターを付けていなかった舟の魚達
の雌もすでにお腹が少し柔らかくなり、雄もすでに追星が出ているものが多く見られました。今
年はやはり産卵が早まりそうです。
探しと雌雄の再確認のために4舟の水換えを行ないました。我が家には瞬間湯沸かし器が無
いのでこの時期の水温合わせには本当に苦労します。ヒーターを付けていなかった舟の魚達
の雌もすでにお腹が少し柔らかくなり、雄もすでに追星が出ているものが多く見られました。今
年はやはり産卵が早まりそうです。
今日は先日お約束のお色気さんとその子達の画像の一部を紹介します。
 |
 |
二枚目の画像は100×90の舟に整理した種雄達10匹の画像です。
4月9日産卵の子達です
この中の8匹はお色気さんの子供達です。錦蘭会の役魚もこの腹から出ました。
ですが・・・。この腹も種魚として期待していた魚は全て雌でした。がっかりです。
全て種としてはどんぐりの背比べです。
気に入ってる魚が全て雌・・・?このままだと雌たちの子孫さえも残せません。
まじにやばいです。
あと一匹!居ることはいます・・・が・・・。それは上の画像の二番目に大きな魚です。この魚、
期待して昨年の春に導入した種雄ですが、昨年は追星が出る事も無く種魚としての役目を全く
果たしてくれませんでした。昨シーズンはプラ舟でイッシー装置を使いかなり無謀ともいえる試
験に参加していまいた。
期待して昨年の春に導入した種雄ですが、昨年は追星が出る事も無く種魚としての役目を全く
果たしてくれませんでした。昨シーズンはプラ舟でイッシー装置を使いかなり無謀ともいえる試
験に参加していまいた。
らんちゅうギャラフォーラムのNO6の12月8日編にちょろっと登場しています。
あ!とそういえばお色気さんもこの試験に参加させていました。
まさか試験に参加させた魚達に今年の重大な役目を担ってもらうとは夢にも思っていませんで
した。お色気さんは4歳ですがすでに臨戦態勢です。今年もやるでしょう。
した。お色気さんは4歳ですがすでに臨戦態勢です。今年もやるでしょう。
昨年のおかまじゃないかなさん(今、命名しました。)はやはり今年も全く追星がでてきません。
これがおかまじゃないかなさんの画像です。
 |
尾皿は少し少なくて前がかりは弱いですが、尾そのものはかなり肉厚でしっかりしています。、
肉留と骨格はさすがに申し分が無いほどに良い魚です。
肉留と骨格はさすがに申し分が無いほどに良い魚です。
次の画像は種雌達です。この中には今年、来年と二歳、親魚で品評用に期待している魚達も
います。
います。
 |
次の画像は以前紹介した自家産の本命魚です。
地元の会の役魚、入賞魚です。ヘルペスが多発した大会の参加魚なので未だに二匹で隔離
飼育を行なっています。産卵後の卵も消毒してヘルペスの蔓延を防ぐ予定です。この二匹は
水温さえ上げればすぐに産卵するほどの状態に仕上がっています。ただ暖冬だった筈の冬が
春を迎えた3月になって長い寒波が訪れています。
飼育を行なっています。産卵後の卵も消毒してヘルペスの蔓延を防ぐ予定です。この二匹は
水温さえ上げればすぐに産卵するほどの状態に仕上がっています。ただ暖冬だった筈の冬が
春を迎えた3月になって長い寒波が訪れています。
この時期の無理な産卵は無駄な電気代と労力を使うために産卵時期は寒波が去ってからと考
えています。一昨年は気がはやって雪が降る中で無理な産卵をさせましたが、苦労ばかり多く
てあまりいい事がありませんでした。
えています。一昨年は気がはやって雪が降る中で無理な産卵をさせましたが、苦労ばかり多く
てあまりいい事がありませんでした。
昨年は半ば自然体で4月8日9日と二腹産卵させましたが、魚を大きくするには、昨年の産卵
時期で充分だと思いましたし、楽でした。
時期で充分だと思いましたし、楽でした。
 |
 |
水温は雄は11度で雌は10.5度の設定を持続します。
<3月18日>
昨日、自家産の本命魚の水換えを行いました。気温は10度でしたが、日差しがあったので午
後の水温は12度でした。こんな水温でもこの二匹はあと少しで産卵しそうです。
後の水温は12度でした。こんな水温でもこの二匹はあと少しで産卵しそうです。
産卵させるでもなし、でも更水の刺激で万が一産卵されてしまえば流すのももったいないので、
この舟だけ水温を16度に設定してたわしをセットしました。
この舟だけ水温を16度に設定してたわしをセットしました。
念のために孵化池にもヒーターを入れて16度にしています。
おかまじゃないかさんは追星を出すのか出さないのか・・・。
微妙なニュアンスです。今日イッシー装置を使っている雄舟に移しました。
画像は自家産本命ペアの今日の様子です。
 |
3月21日
<3月19日>
やはり恐れていた事が起こってしまいました。
水温15.6度で自家産本命魚が産卵してしまいました。
もう少し暖かくなるまで産卵時期を遅らせるつもりだったのですが・・・。
朝の七時に起床何気なく舟を見るとなんと始まってしまっていました。たわしに付着している卵
を見ると白い卵が目立ちます。魚達を洗面器に掬い紫外線の当たらない場所に移動させて人
工授精をしました。人工受精で気をつけなければならないのは水中から魚を取り出して卵と精
子を絞る際に決して紫外線に当てない事です。今回は一寸平べったいボール
を見ると白い卵が目立ちます。魚達を洗面器に掬い紫外線の当たらない場所に移動させて人
工授精をしました。人工受精で気をつけなければならないのは水中から魚を取り出して卵と精
子を絞る際に決して紫外線に当てない事です。今回は一寸平べったいボール
を使ってみましたが、使い勝手は丁度良かったです。
 |
 |
人工受精卵は15分間放置しました。その間に産卵を終えた魚達を養生舟に浮かべて水温合
わせをおこないました。この日の水温は5度でしたので水温合わせには一時間かかりました。
わせをおこないました。この日の水温は5度でしたので水温合わせには一時間かかりました。
 |
 |
上の画像は産卵を終えた魚達と、孵化舟でイソジンによる消毒を行なっているところです。
親魚が万が一でもヘルペスのキャリアーであった場合には精子や卵子の中にはウイルスは存
在しませんが精巣や卵巣の体液の中にはウイルスが存在する可能性があります。(らんぎゃら
フォーラムNo2をご参照下さい。)
在しませんが精巣や卵巣の体液の中にはウイルスが存在する可能性があります。(らんぎゃら
フォーラムNo2をご参照下さい。)
有効沃素濃度が50ppmになるように(イソジンだと200倍希釈)イソジンを丸ごと一本産卵舟
に入れました。結構濃い色なので途中一寸びびりました。しかしこれでもマニュアルより半分ほ
ど薄い濃度です。500ccのイソジンのビンを使ったつもりが250ccのビンと勘違いしていまし
た。
に入れました。結構濃い色なので途中一寸びびりました。しかしこれでもマニュアルより半分ほ
ど薄い濃度です。500ccのイソジンのビンを使ったつもりが250ccのビンと勘違いしていまし
た。
今後は間違わないように気をつけます。
このペアで二番仔もとれるでしょうし・・・(楽観主義)
さて15分の消毒が終われば孵化舟に受精卵を移します。
 |
どうか無事に受精と消毒ができていますように・・・。お目目が出来るまではいつもながら不安
な三日間です。
な三日間です。
3月27日
<3月21日>
長い寒波が去ってようやく春らしくなってきました。
二腹目を採るのがいつになるか分かりませんが、孵化池確保のために今日は三歳以上の魚
を大量に整理しました。
を大量に整理しました。
もう10年近くになりますが、私が要らなくなった魚は、ある中学校を経由して神戸市の小学校
や中学校で飼育されています。私の幼稚園時からの親友が全て仕切ってくれています。ある中
学校では二年前に校庭にビオトープを作りその中で私のらんちゅうが大群で泳いでいます。
や中学校で飼育されています。私の幼稚園時からの親友が全て仕切ってくれています。ある中
学校では二年前に校庭にビオトープを作りその中で私のらんちゅうが大群で泳いでいます。
昨日も夜の7時に中学校へ電話すると彼が電話口に出ました。昨年、教頭先生になってから
何時でも彼が電話に出てくれるので助かります。「親魚を整理したいんだけど、受け入れ出来
る?」「おお。任しとけ。明日休日だけど学校に行くから何時がいい?」早速、今日、魚達が引
き取られていきました。ついでに長い間、(二年半)病院で装置を使って飼育していた魚達もお
役目を終えてどこかの学校で大事に飼育してもらうことになりました。
何時でも彼が電話に出てくれるので助かります。「親魚を整理したいんだけど、受け入れ出来
る?」「おお。任しとけ。明日休日だけど学校に行くから何時がいい?」早速、今日、魚達が引
き取られていきました。ついでに長い間、(二年半)病院で装置を使って飼育していた魚達もお
役目を終えてどこかの学校で大事に飼育してもらうことになりました。
寂しくなりますが全て画像に収めてあります。またの機会ご紹介したいと思っています。
さて心配していた19日に産卵の卵ですが、今日の午後になってお目目が確認できました。
思ったより卵が多すぎて(ざっと5000個)少しだまの部分が気になったので手術用の拡大鏡
で充分な観察を行ないました。だまの部分も90%以上は受精していました。
で充分な観察を行ないました。だまの部分も90%以上は受精していました。
思えば、作秋の品評会の出品後に装置と抗ヘルペス剤を使って養生をさせ、その後もずっと
装置を使い続け、完全に隔離飼育をしてきました。さらに水換えのたびに徹底した消毒も行う
ためにこの舟の水換をするたびに約2時間はかけてきました。この二匹で絶対に仔引きをす
る。その私の決意によくぞここまでこの魚達は応えてくれた・・・・・・・。
装置を使い続け、完全に隔離飼育をしてきました。さらに水換えのたびに徹底した消毒も行う
ためにこの舟の水換をするたびに約2時間はかけてきました。この二匹で絶対に仔引きをす
る。その私の決意によくぞここまでこの魚達は応えてくれた・・・・・・・。
冬眠も冬眠明けも餌も水質も水温も全て同じ条件の中で常に二匹で暮らしてきたのですね。
|
<3月22日>
19日産卵に受精卵ですが洗面器の横にばらけている卵は健康ですが、底の大量の卵はやや
成熟が遅れていようです。その時は水温差で底の部分の水温が低く、発育が遅れているという
程度で楽観していたのですが、思わぬ大惨事が待ち受けていました。時間に追われイソジンに
よる消毒を最優先して初歩的なミスを犯していました。それは頭の中が真っ白になるくらいのミ
スでした。詳細は23日の日記で明らかになります。
成熟が遅れていようです。その時は水温差で底の部分の水温が低く、発育が遅れているという
程度で楽観していたのですが、思わぬ大惨事が待ち受けていました。時間に追われイソジンに
よる消毒を最優先して初歩的なミスを犯していました。それは頭の中が真っ白になるくらいのミ
スでした。詳細は23日の日記で明らかになります。
気分を変えて話はメイン水槽に移ります。
今まで、メイン水槽ではハネ魚のみで試験をしていましたが、今回からは二歳、親魚の品評会
用の魚を作る事をテーマに一匹の魚を選びました。
用の魚を作る事をテーマに一匹の魚を選びました。
またまた長期間の飼育になりますが、試験当初の画像をUPしておきます。
 |
 |
左の画像は上見です。現在のところ、色で損をしていますし筒も細いです。
右の画像は現在の水槽の青水の様子です
ただ、今は筒の細い魚でも装置は筒の太さを作るのには実績があります???
本当かどうか???今後随時、魚の変化を更新していく予定です。
しかし・・・3月23日の日記・・・3月23日の日記・・・・
うーん。やっぱり書きたくない・・・
イッシーの飼育日記(3月25日)
本当に書きたくない日記でした。
<3月23日>
昨日、懸念していた事が現実のものになりました。
たったの1日で下の画像の様になってしまいました。
人工授精そして受精の確認までは順調だったのにこんな結果になってしましました。
どんなに広い舟に洗面器を沈めても僅かな未受精卵が存在すると最初に水生菌、その後は
水生菌さえ死滅する腐敗が洗面器の中で進行します。酸欠による嫌気性菌による硫化水素の
発生でどんどんと受精卵は死んで行き、またそんな中で頑張って孵化した稚魚も洗面器の硫
化水素の毒でどんどん死んでいきます。
水生菌さえ死滅する腐敗が洗面器の中で進行します。酸欠による嫌気性菌による硫化水素の
発生でどんどんと受精卵は死んで行き、またそんな中で頑張って孵化した稚魚も洗面器の硫
化水素の毒でどんどん死んでいきます。
 |
<3月25日>
成功を期待してくれていた皆さんには本当に申し訳ありませんでした。
本当にごめんなさい。
でも誰よりも私自身が落ち込んでいました。もしかしたらヘルペスのキャリアーになっているか
もしれない魚での産卵と消毒。それをおざなりにした為に飼育していた他の舟の魚までも全滅
させてしまった方々も多いと思います。私を含めてそんな方々へのマニュアル作りのつもりで
見事に成功する予定でしたが、初歩での失敗!
もしれない魚での産卵と消毒。それをおざなりにした為に飼育していた他の舟の魚までも全滅
させてしまった方々も多いと思います。私を含めてそんな方々へのマニュアル作りのつもりで
見事に成功する予定でしたが、初歩での失敗!
でも、あえて言います。産卵も消毒も問題はありません。受精卵が高濃度のイソジンで死ぬこ
とはありません。私のミスさえ無ければ皆さんも安心してチャレンジ出来た事だと思います。
とはありません。私のミスさえ無ければ皆さんも安心してチャレンジ出来た事だと思います。
皆さんも大半が私同様にプロのブリーダーでは無いと思っています。
それぞれに自分の仕事を持ち、その中で許された限られた時間でらんちゅう飼育を楽しん
でいると思います。
朝の出勤までの忙しい時間の中でいかに受精率を高め、尚且つ短時間で受精を終わらせる
方法?この失敗からの三日間そればかり考えていました。
まだ試していませんが、やっとひらめきました。イッシー式簡易人工授精法。
魚をさらに整理して試験用に一腹分余計に採るスペースを確保しました。
現在すでにペアリングしています。
今度はイソジンの濃度もさらに高めて完璧な孵化までの様子をご紹介したいと思っていま
す。どうかイッシーを信じて応援して下さいね。
|
